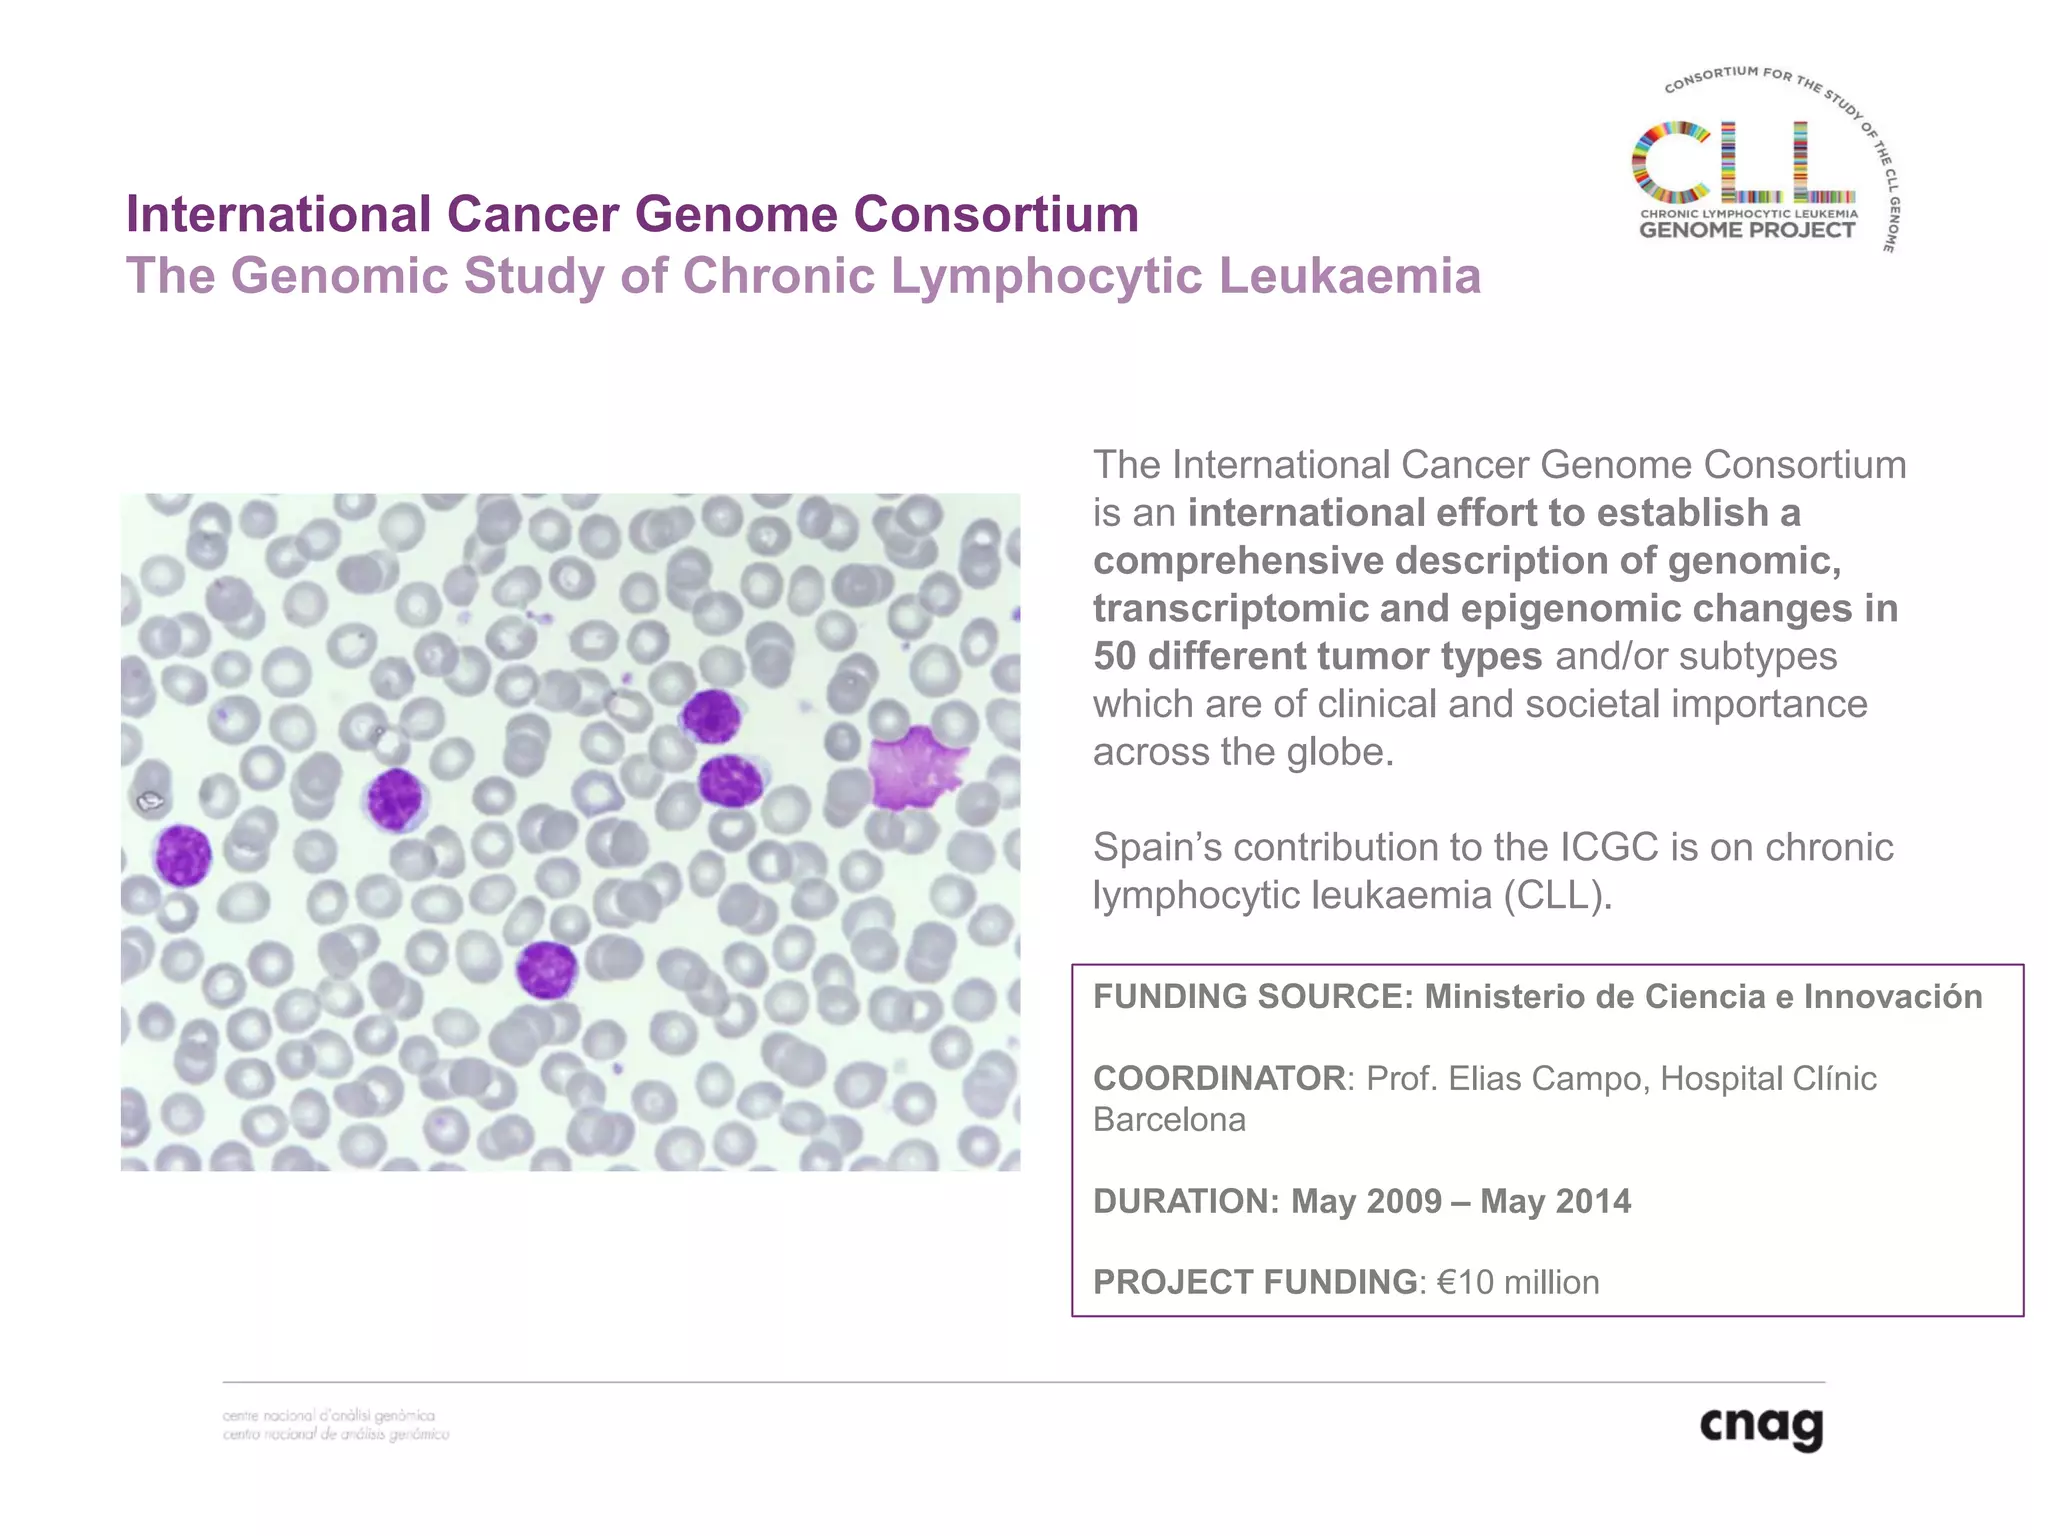
International Cancer Genome Consortium
The International Cancer Genome Consortium
is an international effort to establish a
comprehensive description of genomic,
transcriptomic and epigenomic changes in
50 different tumor types and/or subtypes
which are of clinical and societal importance
across the globe.
Spain’s contribution to the ICGC is on chronic
lymphocytic leukaemia (CLL).
FUNDING SOURCE: Ministerio de Ciencia e Innovación
COORDINATOR: Prof. Elias Campo, Hospital Clínic
Barcelona
DURATION: May 2009 – May 2014
PROJECT FUNDING: €10 million

Embed presentation
Downloaded 41 times


















































The document provides information about a short course on next generation sequencing and analysis of sequence variants. It includes an agenda with sessions on introduction to NGS applications in medical research, data analysis pipelines, interpretation of variants, and tools for predicting pathogenicity. It also provides background on the organizing institutions, the CNAG sequencing center and its projects, and an overview of bioinformatics analysis pipelines and resources.